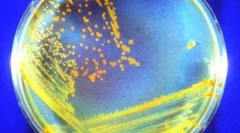
Бесмртни животни кои ќе преживеат сите нас

Која птица може да лета подолго од сите без одмор?

Во светот на птиците, постои најнепознатлив, активен и енергетски поин - Црна Стриж. Оваа мала птица која живее во Централна Европа и Азија и може да развие огромна брзина - до 180 км / ч, исто така, се разликува во тоа што е буквално целиот свој живот "на крилја".
Без слетување за една минута (неколку години може да се одржи во состојба на постојан лет), тој прави се што е потребно за живот на мува - јаде, пие, па дури и - што е особено изненадувачки - спие! Орнитолозите откриле дека пред првиот пат да биде на земјата, црните фризури треба да летаат најмалку половина милион километри.
Треба да се напомене дека црна низа не е рамнодушен кон "населен" начин на живот - едноставно не е прилагоден на него: не знае како да одиме по земјата и полетување со рамна површина.